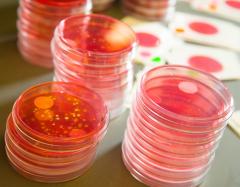
Micro Plates

Microbiological Testing
 Product safety is a key concern in the minds of food manufacturers as well as consumers and all stakeholders in the supply chain.
Product safety is a key concern in the minds of food manufacturers as well as consumers and all stakeholders in the supply chain.
Determining quality, safety and risk can all be performed by our microbiological testing laboratory. Food-borne pathogen testing, shelf life determination and challenge studies, environmental testing, identifying process or preservative system failures, food station and plant sanitation process verification are some of the staple procedures carried out by our microbiological testing service.
Shelf Life Testing
From fresh, refrigerated and frozen products to shelf-stable products and processed meats, all food products have an optimal time during which the customer should consume it, both for safety and quality purposes.
From fresh, refrigerated and frozen products to shelf-stable products and processed meats, all food products have an optimal time during which the customer should consume it, both for safety and quality purposes.
Risk Assessment
Pathogens are one of the main concerns to the consumer. Validation studies can be done to ensure your process is appropriate and results in a safe, acceptable product to the consumer.
Please contact us at fsic@uky.edu or (859) 218-4387 to discuss and/or develop Microbiological Testing.